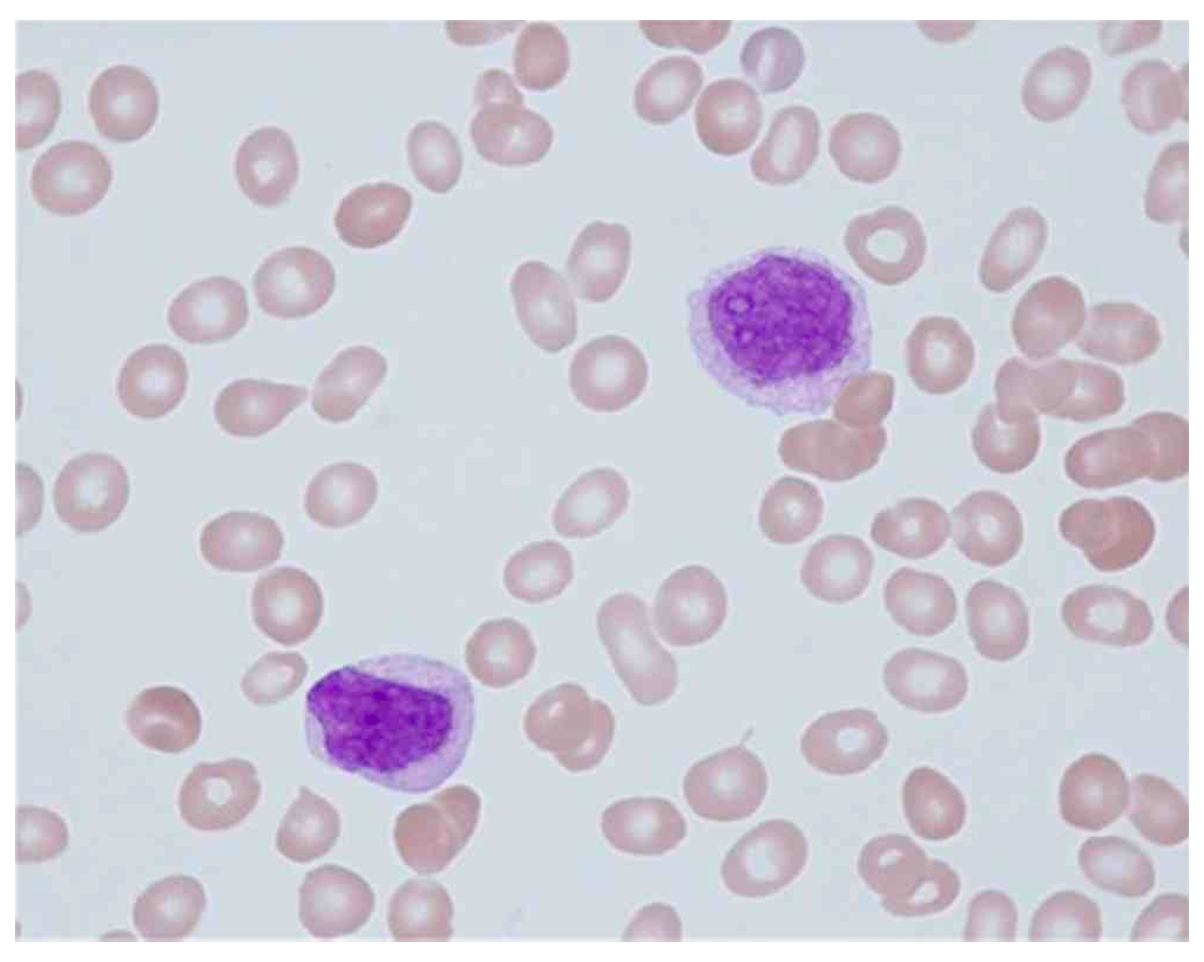
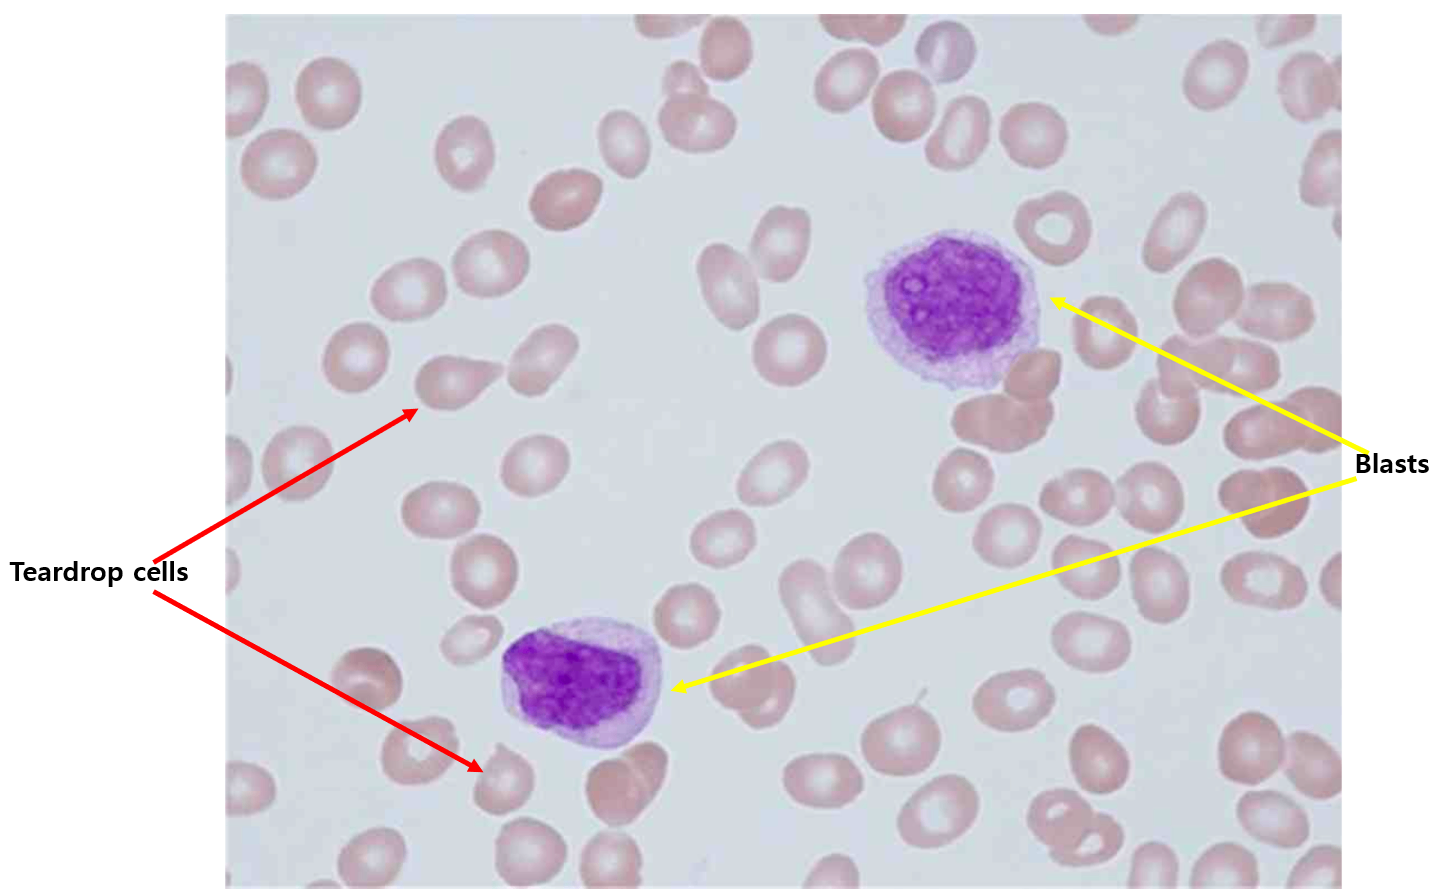

46번
[MD25]
0
26세 여자가 1주 전부터 코피가 반복된다며 병원에 왔다. 3~4주 전부터 입맛이 없고, 체중이 3 kg 줄었다. 부딪힌 기억이 없는데 멍이 생겼다고 한다. 5일 전 시작한 생리는 양이 많고 멈추지 않는다. 혈압 100/60 mmHg, 맥박 108회/분, 호흡 20회/분, 체온 36.5°C이다. 팔과 다리에서 점출혈과 멍이 관찰된다. 혈액검사 결과는 다음과 같다. 말초혈액펴바른표본이다. 치료는?
혈색소 7.3 g/dL, 백혈구 3,400/mm3, 혈소판 15,000/mm3
총단백질 6.8 g/dL, 알부민 3.4 g/dL
혈액요소질소/크레아티닌 22.0/1.3 mg/dL
젖산탈수소효소 380 U/L (참고치, 115~ 221)
C반응단백질 15 mg/L (참고치, <10)
정답률 49%
누적 풀이 횟수 2,600+
평균 풀이 시간55초
/
나의 풀이 시간0초
CC | F/26, 반복적 코피(1w) |
Hx | |
S/Sx | 식욕저하, 체중감소(-3kg), 멍이 쉽게 듦(3~4w), 월경과다(5d) V/S 100/60 108 20 36.5, multiple bruises/petechiae on extremities |
Lab | Hb↓, WBC↓, PLT↓, LDH↑, CRP↑ |
Img | |
Etc | PB smear: Teardrop cells, blasts |
Imp: R/O 급성 백혈병(acute leukemia)
해설
혈액검사 상 pancytopenia가 보이며 LDH 상승 및 PB smear에서 blast가 보이므로 급성 백혈병 의심하, 현재 과다월경, 코피, petechiae, bruises 등 현성 출혈이 있으며 혈소판 수치가 15,000/mm3 로 감소하였으므로 혈소판 수혈로 현성 출혈을 치료한다.
• 26세 여자가 1주 전부터 시작된 반복적인 코피를 주호소로 내원하였다.
• 환자는 3~4주 전부터 쉽게 멍이 들고, 5일 동안 과다월경이 있으며, 팔과 다리에 점출혈과 멍이 관찰되므로 지혈장애가 있음을 확인할 수 있고 특히 점출혈이 관찰되는 점을 통해 1차 지혈장애가 있음을 확인할 수 있다.
• 1차 지혈장애의 대표적 원인은 혈소판 감소이므로 CBC를 시행해야 하며 CBC 상 Hb, WBC, PLT 모두 감소된 pancytopenia가 보인다. 따라서 환자의 1차 지혈장애의 원인은 혈소판 감소임을 확인할 수 있다.
• 환자의 체중감소와 CBC 상 pancytopenia, 혈액검사 상 LDH 상승으로부터 백혈병 등 악성 혈액질환을 의심해야 하며 진단을 위해 PB smear을 실시하였다.
• PB smear 상 blasts가 보이며 teardrop cells이 보이므로 환자의 혈소판 감소의 원인은 급성 백혈병임을 알 수 있다.
• 현재 환자는 출혈 경향성이 있는 상태이며 혈소판 수치가 15,000/mm3 로 감소하였으므로 혈소판 수혈로 현성 출혈을 치료한다.
Tip
• 본 증례는 급성 백혈병의 확진을 위해 골수검사가 필요하다. (참고 혈소판감소증의 접근)
• Teardrop cell(dacrocyte)과 연관된 질환으로 hemolytic anemias, severe iron deficiency, thalassemias, myelofibrosis, and myelodysplastic syndromes(MDS), AML이 있다. 본 증례의 teardrop cell은 AML로 인한 병변으로 추정된다. ALL의 경우 AML과 달리 teardrop cell이 보이지 않는다. MDS와 AML은 비슷한 질환이지만, AML의 경우 골수에 blast > 20%인 점이 다르다.
• 1차 지혈장애 vs 2차 지혈장애
• 혈액제제 투여 기준 요약
오답 선지
• 글루코코티코이드, 면역글로불린정맥주사 : ITP의 치료법으로 현재 환자는 출혈과 함께 급성 백혈병에 의한 PLT 감소가 있으므로 즉각적인 혈소판 수혈이 필요하다.
• 신선냉동혈장 수혈 : PT, aPTT가 증가한 2차 지혈장애에서 응고인자를 보충하는 치료제로 PLT 감소가 있는 1차 지혈장애에서는 사용하지 않는다.
• 혈소판형성인자수용체작용제 : 혈소판 활성화 인자(platelet-activating factor, PAF)를 활성화하는 약제로 출혈질환에서 거의 사용되지 않는다.
관련 이론
• 백혈병
• 출혈질환의 접근 및 진단
Reference
• Harrison 21e, pp.450-457, 809-840